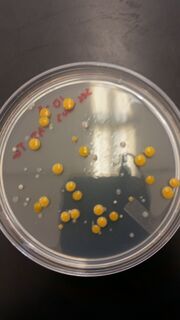
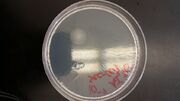

Uploads by Allen D. Irving
From OpenWetWare
Jump to navigationJump to search
This special page shows all uploaded files.
| Date | Name | Thumbnail | Size | Description |
|---|---|---|---|---|
| 13:42, 17 February 2016 | 20160211 133807.jpg (file) |  |
2.64 MB | |
| 13:41, 17 February 2016 | 20160211 132655.jpg (file) |  |
2.89 MB | |
| 13:40, 17 February 2016 | 20160211 131611.jpg (file) |  |
2.85 MB | |
| 23:20, 10 February 2016 | 20160204 135040.jpg (file) |  |
3.42 MB | |
| 23:05, 10 February 2016 | 20160204 124123.jpg (file) |  |
5.9 MB | |
| 23:03, 10 February 2016 | 20160204 134047.jpg (file) |  |
2.25 MB | |
| 23:00, 10 February 2016 | 20160204 124239.jpg (file) |  |
4.63 MB | |
| 16:14, 10 February 2016 | 20160204 133714.jpg (file) |  |
3.03 MB | |
| 16:14, 10 February 2016 | 20160204 124311.jpg (file) |  |
5.41 MB | |
| 16:01, 10 February 2016 | 20160204 124516.jpg (file) |  |
5.38 MB | |
| 15:54, 10 February 2016 | 20160204 124348.jpg (file) |  |
4.82 MB | |
| 04:30, 4 February 2016 | Gram negative 10^-3 yellow with TET.jpg (file) |  |
4.2 MB | |
| 04:29, 4 February 2016 | Gram positive 10^-3 with TET.jpg (file) |  |
2.77 MB | |
| 04:28, 4 February 2016 | Gram negative 10^-5 non-TET.jpg (file) |  |
3.87 MB | |
| 04:26, 4 February 2016 | Gram negative 10^-3 non-TET.jpg (file) |  |
3.81 MB | |
| 04:25, 4 February 2016 | 10^-3 with TET.jpg (file) | |
3.35 MB | |
| 04:23, 4 February 2016 | 10^-7 non-TET.jpg (file) | |
3.32 MB | |
| 04:22, 4 February 2016 | 10^-5 non-TET.jpg (file) |  |
3.51 MB | |
| 04:20, 4 February 2016 | 10^-3 non-TET.jpg (file) |  |
4.03 MB | |
| 04:19, 4 February 2016 | Final Hay Infusion.jpg (file) |  |
3.41 MB | |
| 02:12, 28 January 2016 | Hay Infusion Microscope .JPG (file) |  |
1.68 MB | |
| 02:10, 28 January 2016 | Hay Infusion .jpg (file) |  |
3.73 MB | |
| 02:06, 28 January 2016 | Document-1.pdf (file) | 105 KB | ||
| 01:03, 21 January 2016 | Scanned Terasect Image.pdf (file) | 80 KB |